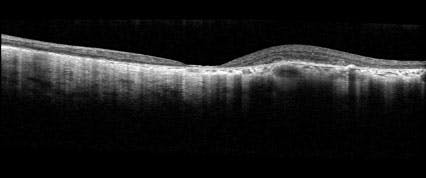

AT A GLANCE
- Choroideremia is an x-linked chorioretinal dystrophy with an overall prevalence of one in 50,000 men.
- Fluorescein angiography reveals hypofluorescent areas of missing choriocapillaris with adjacent hyperfluorescent areas of perfused choriocapillaris.
- A few observational and interventional clinical trials are underway, many in conjunction with retinitis pigmentosa.
MORE RESOURCES

Foundation Fighting Blindness provides important educational resources for you and your patients, including disease state education, genetic testing, and clinical trial updates.
Choroideremia is an x-linked chorioretinal dystrophy with an overall prevalence of one in 50,000 men.1 It is characterized by progressive degeneration of the retinal pigment epithelium (RPE), choroid, and photoreceptors, resulting in significant visual impairment. The condition is primarily caused by a loss of the RPE, followed by the secondary degeneration of photoreceptors and choroidal atrophy.2 It is caused by mutations in the CHM gene (Xq21.2), encoding for Rab escort protein 1 (REP1), a 653 amino acid polypeptide that mediates lipid modifications of specific G proteins regulating intracellular trafficking of proteins, substrates, and organelles.3 Although REP1 is expressed ubiquitously, the condition appears only to affect the RPE layer of the eye, resulting in the characteristic clinical phenotype.
CLINICAL PRESENTATION
Symptoms often arise during the first decade of life, with night blindness and visual field loss, progressively worsening until legal blindness occurs around the fifth to seventh decade of life.4 Ophthalmoscopic findings include widespread pigment clumping as the earliest manifestation, long before photoreceptor loss. At later stages, the typical fundus findings of well-defined centripetal atrophic areas can be appreciated (Figure 1).

Figure 1. Patchy, centripetal atrophic areas with clumped pigmentary changes are notable on fundus examination in this patient with CHM mutation. The optic nerve and retinal vessels appear unaffected.
Degeneration begins at the equator, with progressive centripetal retinal and choroidal degeneration extending toward the anterior retina and posterior pole, which are hallmarks of the disease. The condition is bilateral and usually symmetric. Interestingly, while the depletion of the choriocapillaris is reported, the large choroidal and retinal vessels appear unaffected, and there is no optic nerve atrophy.5,6 These clinical findings, as well as positive genetic testing, are useful to establish the diagnosis.
Functional scotopic vision loss and midperipheral visual field loss often begin during the first and second decades of life. Nevertheless, visual acuity in not affected until the late stage, when degeneration progresses to the fovea.7 Cystoid macular edema has been described in up to 62.5% of affected patients and is usually treated with a topical carbonic anhydrase inhibitor, such as dorzolamide.8 Additionally, patients may present with cataract and, rarely, macular neovascularization.9
Of note, female carriers of the CHM mutation are usually asymptomatic. Occasionally, female carriers can present with retinal abnormalities ranging from mild RPE changes to patchy RPE degeneration with areas of atrophy and functional impairment in more severe cases, resulting from X-chromosome inactivation.10,11
MULTIMODAL IMAGING
Fluorescein angiography reveals hypofluorescent areas of missing choriocapillaris with adjacent hyperfluorescent areas of perfused choriocapillaris. Hypoautofluorescent areas on fundus autofluorescence correspond to affected retina (Figure 2).12 Furthermore, a granular pattern of hypoautofluorescence can be seen in early cases and carriers.13

Figure 2. The characteristic patchy circular centripetal atrophic pattern can often be better appreciated with fundus autofluorescence. In this advanced case of choroideremia, disease progression threatens the foveal area. Good central visual acuity is often preserved until the later stages of disease.
OCT shows preservation of the inner retinal layer despite disease progression. However, changes in the retinal and choroidal thickness may be observed, with a small increase in central retina thickness in early disease followed by progressive subfoveal thinning. Conversely, choroidal thickness is reduced throughout disease progression. Over time, retinal tubulation in the outer nuclear layers may develop, along with inner retinal microcysts and cystoid macular edema.8 Although rare, macular neovascularization can develop; therefore, careful follow-up is warranted (Figure 3).9
Figure 3. OCT demonstrates reduced retinal and choroidal thickness, as well as disorganization of retinal layers and extensive atrophy in this patient with choroideremia. OCT is useful to monitor for the occurrence of central macular edema and other conditions.
CLINICAL TRIALS
A few observational and interventional clinical trials are underway, many in conjunction with retinitis pigmentosa (RP). ENVISION is a phase 1 clinical trial (NCT06460844) evaluating the role of intravitreal delivery of RTX-015 (Ray Therapeutics), an optogenetic gene therapy, in patients with choroideremia or RP.
ABACUS (NCT05282953) is a phase 1/2 clinical trial evaluating the intravitreal delivery of KIO-301 (Kiora Pharmaceuticals), a gene-agnostic photoswitch, in patients with choroideremia or RP. Data from the trial showed that KIO-301 has the potential to meaningfully improve vision for treated patients, and the company has initiated a phase 2 ABACUS-2 trial (NCT06628947), which is specific to patients with RP.14
Stem cell therapy is mainly being investigated in advanced disease.10
Moreover, while the role of vitamin A modifications in halting disease progression is currently being studied, to date, there is no treatment available for affected patient.10,13
1. Pennesi ME, Birch DG, Duncan JL, Bennett J, Girach A. Choroideremia: retinal degeneration with an unmet need. Retina. 2019;39(11):2059-2069.
2. Tolmachova T. Independent degeneration of photoreceptors and retinal pigment epithelium in conditional knockout mouse models of choroideremia. J Clin Invest. 2006;116(2):386-394.
3. Van Den Hurk J, Schwartz M, Van Bokhoven H, et al. Molecular basis of choroideremia (CHM): Mutations involving the rab escort protein-1 (REP-1) gene. Hum Mutat. 1997;9(2):110-117.
4. Kalatzis V, Hamel CP, MacDonald IM. Choroideremia: towards a therapy. Am J Ophthalmol. 2013;156(3):433-437.e3.
5. Khan KN, Islam F, Moore AT, Michaelides M. Clinical and genetic features of choroideremia in childhood. Ophthalmology. 2016;123(10):2158-2165.
6. Coussa RG, Traboulsi EI. Choroideremia: A review of general findings and pathogenesis. Ophthalmic Genetics. 2012;33(2):57-65.
7. Aleman TS, Han G, Serrano LW, et al. Natural history of the central structural abnormalities in choroideremia. Ophthalmology. 2017;124(3):359-373.
8. Genead MA, Fishman GA. Cystic macular oedema on spectral-domain optical coherence tomography in choroideremia patients without cystic changes on fundus examination. Eye. 2011;25(1):84-90.
9. Valastro A, Romano F, Salvetti AP. Macular neovascularization in choroideremia. Ophthalmol Retina. 2023;7(7):604.
10. Mitsios A, Dubis AM, Moosajee M. Choroideremia: from genetic and clinical phenotyping to gene therapy and future treatments. Ophthalmol Eye Dis. 2018;10:2515841418817490.
11. Gocuk SA, Ayton LN, Edwards TL, et al. Longitudinal assessment of female carriers of choroideremia using multimodal retinal imaging. Br J Ophthalmol. 2025;109(2):293-299.
12. Cehajic Kapetanovic J, Barnard AR, MacLaren RE. Molecular therapies for choroideremia. Genes. 2019;10(10):738.
13. Pichi F, Abboud EB, Ghazi NG, Khan AO. Fundus autofluorescence imaging in hereditary retinal diseases. Acta Ophthalmologica. 2018;96(5):e549-e561.
14. AAO late-breaking: Kiora's small molecule photoswitch demonstrates meaningful vision improvements in blind patients with retinitis pigmentosa [press release]. Kiora Pharmaceuticals. November 4, 2023. Accessed June 30, 2025. bit.ly/449rWsI
























